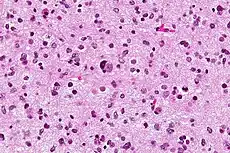

星形膠質細胞
星形膠質細胞(astrocyte)简称星形细胞、星状细胞[1],统称星形胶质(astroglia),是存在于脑和脊髓中呈星状的一种神經膠質細胞(glia)。它們執行着許多功能,包括对形成血腦屏障的內皮細胞进行生化控制、向神經組織提供營養、維持細胞外離子平衡、调节脑血流量(CBF),以及在修复脑和脊髓因感染或物理伤害形成的损伤、形成胶质瘢痕的过程中发挥重要作用。星形膠質細胞在大腦中的比例尚不明確。基于不同的计量方法,研究表明星形膠質細胞的比例因區域而異,佔所有神經膠質細胞的20%至40%[2]。但也另有研究认为星形胶质细胞是大脑中含量最多的细胞类型[3]。星形胶质细胞是中枢神经系统(CNS)中胆固醇的主要来源,载脂蛋白E将胆固醇从星形胶质细胞运输到神经元和其他胶质细胞,调节大脑中的细胞信号传送[4]。人类的星形胶质细胞比啮齿类动物的大20多倍,形成的突触数量是啮齿类动物的10多倍[5]。
| 星形膠質細胞 | |
|---|---|
![]() 星形膠質細胞可在人工培養環境下以螢光方式顯現,因為與其他膠質細胞相同,它們有表達膠質纖維酸性蛋白 | |
| 基本 | |
| 发育自 | 成胶质细胞 |
| 位置 | 脑、脊髓 |
| 标识字符 | |
| 拉丁文 | Astrocytus |
| MeSH | D001253 |
| NeuroLex ID | sao1394521419 |
| TH | H2.00.06.2.00002、H2.00.06.2.01008 |
| FMA | FMA:54537 |
| 《显微解剖学术语》 | |
自1990年代中期的研究表明,星形膠質細胞受到刺激时可在细胞间遠距離傳播Ca2+波,并且,類似於神經元,以Ca2+依赖的方式釋放神经递质(称为胶质遞質 (Gliotransmitter)) [6] 。數據表明,星形膠質細胞還會通過鈣離子依賴的路径释放穀氨酸,向神經元發出信號[7] 。這些發現使星形膠質細胞成為神經科學领域的重要研究方向。
構造


星形膠質細胞是中樞神經系統中神經膠質細胞的一種亞型。 它們的許多過程都包裹著神經元產生的突觸。傳統上會使用組織學分析去鑑定星形膠質細胞。細胞往往會表達中間絲狀的膠質纖維酸性蛋白(GFAP) [8] 。GFAP的上調往往代表著反應性星形膠質細胞增生 (reactive astrogliosis) [9],即是中樞神經系統損傷中非常普遍的現象,其增生的輕重程度取決於損傷部位的病理、生理環境[10]。
在中樞神經系統中,會存在着幾種形式的星形膠質細胞,包括纖維狀、原生質及放射狀。纖維性星形神經膠質細胞 (星形膠質細胞I型) 通常位於白質內,細胞器相對較少,並表現出細長而無分支的細胞突起,細胞內有大量膠質絲。這種類型的星形膠質細胞通常具有“血管腳”,故而當它們靠近微血管壁時,它們會將細胞以物理形式連接到微管壁的外部。原漿性星形神經膠質細胞 (星形膠質細胞II型) 普遍見於灰質組織中,具有大量的細胞器,並表現出粗短而多分支的細胞突起,細胞內的膠質絲亦較少。在20世紀中期,透過電子顯微鏡分析,原漿型星形膠質細胞包裹軸突,而纖維性星形膠質細胞則與Ranvier節發生聯繫,2種亞型的星形膠質細胞均能在鄰近的星形膠質細胞之間進行填充而形成連接,兩種細胞均與血管發生廣泛的聯繫[11]。放射狀星形神經膠質細胞 (伯格曼膠質細胞) 是自腦室區延伸至軟腦膜之放射狀突出物。
神經膠質細胞大多數只會在發育過程中出現,在神經元遷移的過程起一定的作用,惟視網膜的缪勒氏细胞和小腦皮層的放射狀膠質細胞是一個例外,在成年期仍然存在。 當接近軟膜時,所有形式的星形膠質細胞都會發出形成膠體神經膠質膜 (pia-glial membrane) 的突起。

星形膠質細胞乃透過鈣來互相傳遞訊息。星狀細胞因彼此之間有隙型連接(亦稱為電性突觸),因此訊息分子例如肌醇三磷酸(IP3)可以自由地由一個星狀細胞擴散到另一個細胞。IP3引發的傳訊路徑會開啓細胞內胞器上的鈣離子通道,讓鈣離子進入細胞質。這些鈣離子可能再促發更多IP3的產生。這個反應的淨結果為創造一股鈣離子波在細胞間傳遞。星狀細胞於胞外釋放三磷酸腺苷(ATP),並且活化其他星狀細胞的嘌呤受體,在某些情況下也可能產生此種鈣離子波。
縫隙連接蛋白43 (Cx43)是構成星形膠質細胞間縫隙連接的主要蛋白質,允許離子和分子量小於1 kD或直徑小於1.5 nm的小分子物質 (如cAMP、IP3、H2O等) 自由擴散進入相鄰的細胞,故而是細胞間物質和信息跨膜傳遞的重要通道[12]。

正常情況下星形膠質細胞分為靜止態、活化態和增殖態,三者相互轉換構成了廣義上的細胞週期。在正常的中樞神經系統中,靜止態和活化態的膠質細胞並存。當受到損傷時,在細胞因子作用下,靜止態的細胞逐漸向活化態轉化[13]。
發育

星形膠質細胞是中樞神經系統中的大膠質細胞。星形膠質細胞源於發育中的中樞神經系統神經上皮細胞 (neuroepithelium) 中的祖細胞異質群體 (heterogeneous populations ) 。在指定多種神經元亞型譜系和大膠質細胞譜系的遺傳機制之間,存在著顯著的相似性[14] 。典型的信號傳導因子,例如音蝟因子(SHH)、成纖維細胞生長因子(FGFs)、WNTs和骨塑型蛋白(BMPs),可以通過沿着背-腹軸、前-後軸和內-側軸的生長素梯度 (morphogen gradients) 為發育中的大膠質細胞提供了位置信息。沿神經軸形成的圖案會導致在發育中的脊髓中,神經上皮細分為不同神經元類型的區域 (progenitor domains) 。例如p0、p1、p2、p3和pMN)。根據研究顯示,該模型也適用於大膠質細胞,同時也有研究表明,p1,p2和p3結構域產生了三個不同的星形膠質細胞群體[15] 。已確定的三種星形膠質細胞亞型群。第一種為背側、位於VA1的星形膠質細胞,源自p1結構域,表達PAX6和絡絲蛋白。第二種為背側、位於VA3的星形膠質細胞,源自p3結構域,表達NKX6-1和SLIT1。第三種為中間是白色物質、位於VA2的星形膠質細胞,源自p2結構域,表達PAX6、NKX6-1、絡絲蛋白和SLIT1[16] 。 星形膠質細胞的亞型可以根據它們在不同轉錄因子(PAX6、NKX6.1)和細胞表面標誌(絡絲蛋白和SLIT1)的表達來確定,故而可以分為三種星形膠質細胞亞型群。
在發育中的CNS中,當星形膠質細胞規格出現後,星形膠質細胞前體就會在發生終末分化過程前,遷移到它們在神經系統內的最終位置。
在星形膠質細胞中,早期反應生長因子-1可調控多種細胞因子的表達,如膠質細胞源性神經營養因子(GDNF)、鹼性成纖維細胞生長因子 (bFGF)、表皮生長因子 (EGF) 及血小板衍生生長因子 (PDGF) 等,進而促進細胞的增殖[17][18]。
功能

星形膠質細胞幫助形成大腦的物理結構,並且積極發揮着許多作用,包括神經遞質的分泌或吸收,以及對血腦屏障的維持[20]。三方突觸的概念已經被學者提出,指的是突觸前元件、突觸後元件和神經膠質元件之間在突觸處發生的緊密關係[21]。
- 結構方面 : 他們參與大腦的物理結構化。 星狀細胞之所以得名是因為它們是“星形”的。 它們是大腦最多的神經膠質細胞,與神經元突觸具有密切關係,負責調節腦內電脈衝的傳輸。
- 作為糖原儲備:星狀細胞含有糖原,並具有糖質新生的能力。 額葉皮層和海馬中,神經元旁邊的星形膠質細胞儲存並釋放葡萄糖,故而在高葡萄糖消耗率和葡萄糖短缺期間,星形膠質細胞可以為神經元提供葡萄糖。 部分學者對老鼠的研究表明,這種活動與體育鍛煉之間可能存在着一定的聯繫[22]。

- 幫助代謝:它們為神經元提供營養,例如乳酸、葡萄糖等。超微結構研究顯示,腦實質內所有的毛細血管都被AS的終足包裹,這一結構提示AS是腦部攝取血液葡萄糖的最初部位。雖然在生理條件下,腦部產生的能量約百分之九十至九十五被神經元所消耗,但是約百分之八十的腦葡萄糖利用正是在AS發生。葡萄糖需要在AS中酵解加工產生乳酸,以乳酸鹽的形式為神經元提供能量。神經元興奮時,可釋放興奮遞質穀氨酸,榖氨酸與Na+通過星形膠質細胞膜受體進入細胞,同時Na+的升高激活Na+-K+-ATP酶,並且在葡萄糖轉運蛋白的協助下,吸收葡萄糖並進行酵解,釋放乳酸鹽[23]。AS具有在有氧條件下代謝葡萄糖生成乳酸的特性,稱為有氧糖酵解。由於神經元自身的糖酵解能力較低,其乳酸主要來自於AS,AS與神經元之間存在着星形膠質細胞-神經元乳酸穿梭 (ANLS) [24]。

- 血腦屏障:包圍着內皮細胞的星形膠質細胞末端腳被認為有助於維持血腦屏障,但最近的研究表明它們並未發揮實質性作用。取而代之的是,大腦內皮細胞的緊密連接和基板在維持屏障中起著最重要的作用[26],惟最近發現以功能性磁振造影 (fMRI) 測量後的星形膠質細胞的活動與大腦中的血流有關係[27][28]。
- 遞質的攝取和釋放:星形膠質細胞表達質膜轉運體 (plasma membrane transporters ) ,例如穀氨酸、ATP和γ-氨基丁酸等幾種神經遞質的穀氨酸轉運體。 最近的研究顯示,星形膠質細胞會以囊泡、Ca 2 + 依賴性的方式釋放穀氨酸或ATP[29] ( 海馬的星形膠質細胞在此方面存在爭議[30]。)
- 細胞外離子濃度的調節:星形膠質細胞高密度地表達鉀離子通道。 當神經元活躍時,它們就會釋放鉀離子,從而增加局部細胞外的濃度。 由於星形膠質細胞對鉀具有很高的滲透性,因此它們可以迅速清除細胞外空間中的過量積累物。[31] 。如果該功能受到干擾,從戈德曼方程可知會導致鉀在細胞外的濃度升高,導致神經元去極化。如果細胞外有鉀的異常積累,會導致癲癇的神經元活動[32]。在中樞神經系統中,星形膠質細胞通過L-穀氨酸-天門冬氨酸轉運體 (GLAST) 和榖氨酸轉運體 (GLT-1) 對細胞間隙的谷氨酸進行攝取,維持胞外正常的興奮性神經遞質濃度。持續高濃度的榖氨酸環境可促使小膠質細胞和星形膠質細胞NF-κB激活,誘導致炎基因合成使炎性反應擴大,成為許多神經系統炎性疾病及神經退行性疾病的病理機制[33]。
- 神經鏈傳導的調節:在下丘腦的視上核中,星形膠質細胞形態的快速變化會影響神經元之間的異突觸傳遞 (heterosynaptic transmission) [34] 。海馬的星形膠質細胞通過釋放ATP,以抑制突觸傳遞,ATP被CD73外核苷酸酶水解成腺苷。 腺苷作用於神經元腺苷受體以抑制突觸傳遞,從而增加了長期增強作用的動態範圍[35]。
- 血管調節:星形膠質細胞可以作為神經元調節血流的媒介[36] 。
- 促進寡突膠質細胞髓鞘活動:神經元的電流使它們釋放ATP,這是形成髓鞘的重要刺激。 ATP並不直接作用於寡突膠質細胞,反而它會導致星形膠質細胞分泌白血病抑制因子(LIF),可以促進寡突膠質細胞的髓鞘形成活性,表明星形膠質細胞在大腦中具有協調作用[37]。
- 修復神經系統:中樞神經系統中的神經細胞受到損傷後,星形膠質細胞會填滿空間,形成神經膠質疤痕上,可能有助於神經修復。 星形膠質細胞在中樞神經系統再生中的作用尚不清楚。 傳統上將神經膠質瘢痕描述為再生的不可滲透的屏障,暗示了軸突再生 (axon regeneration) 的負面作用。 近年部分研究發現,星形膠質細胞是再生所必需的[38] 。更重要的是,他們發現星形膠質瘢痕對於被刺激的軸突 (stimulated axons) 延伸穿過受傷的脊髓來說至關重要[38]。當星形膠質細胞增生發生時,此可能對神經元有毒,釋放出可以殺死神經元的信號[39]。目前尚需更多研究來闡明它們在神經系統損傷中的作用。
- 長期增強作用:星形膠質細胞是否整合了海馬體的學習和記憶能力引起部分學者的爭論。 近年的研究發現,將人類神經膠質祖細胞移植到新生老鼠的大腦中會導致該細胞分化為星形膠質細胞。 這些細胞在分化後,不僅會增加了長期增強作用,還會改善老鼠的記憶力[40]。
- 神經系統的開關:部分學者指出大神經膠質細胞(特別是星形膠質細胞)既是有損的神經遞質容器 (lossy neurotransmitter capacitor) ,又是神經系統的邏輯轉換器 (logical switch) ,故而膠質細胞會根據其膜狀態和刺激水平阻止刺激傳播,抑或使刺激沿著神經系統傳播[42]。

| 證據類別 | 描述 | 資料來源 |
|---|---|---|
| 鈣 | 鈣波僅在超過一定濃度的神經遞質出現時才發生。 | [44][45][46] |
| 電生理學 | 當刺激水平超過某個閾值時會出現一個負波。電生理反應的形狀是不同的,並且與特徵性神經反應相比具有相反的極性,這表明除了神經元外,其他細胞也可能參與其中。 | [47][48][49][50] |
激活
臨床顯著性
星狀細胞瘤
星狀細胞瘤是最常見的神經上皮性腫瘤,並且是從星形膠質細胞發展而來的腦腫瘤,神經膠質祖細胞或神經乾細胞也可能引致星形細胞瘤。星形細胞瘤可發生在中樞神經系統的任何部位,成年人以幕上大腦半球居多,兒童則以幕下小腦常見。發生在幕上者以額葉及顳葉多見,有時甚至可以累積多個腦葉,亦可見於視神經,丘腦和第三腦室旁。幕下者則以小腦半球和第四腦室多見,亦可發生於蚓部和腦幹[58]。星形細胞瘤分為兩類:低度(I和II)和高度(III和IV)。低度腫瘤屬於分化不良的星形細胞瘤,在兒童中更為常見,此級別的腫瘤通常病程進展較緩,顯微外科手術治療預後亦較好;而高度腫瘤是多形性膠質母細胞瘤,在成人中更為常見,此級別的腫瘤通常惡性程度高[59] 。

毛狀星細胞瘤是I級腫瘤,被認為是良性和緩慢生長的腫瘤,通常具有充滿液體的固體結節部分和結節,大多數位於小腦、第三腦室底部及靠近視神經附近,故而大多數症狀與平衡或協調困難有關[59]。它們在兒童和青少年中也更為常見[60]。星細胞瘤屬於生長相對較慢的II級腫瘤,為纖維狀或原生質性星形細胞瘤 (Fibrillary or Protoplasmic astrocytomas),通常被認為是良性的,但會侵襲周圍的健康組織,可以長成惡性腫瘤。它們在年輕人中更為常見[60]。分化不良星細胞瘤 (Anaplastic astrocytoma) 被分類為III級並且是惡性腫瘤。 它們比低等級的腫瘤生長更快,並且傾向於侵入附近的健康組織。 分化不良星形細胞瘤的複發率比低等級腫瘤高,因此很難通過手術及放射線治療徹底清除[59]。多形性神經膠質母細胞瘤 (Glioblastoma Multiform、GBM ) 被分類為IV級並且是惡性腫瘤,可以包含一種以上的細胞類型,如少突膠質細胞等。儘管一種細胞類型可能會因特定治療而死亡,但其他細胞類型可能會繼續繁殖,並且擴散到附近組織,故而是膠質瘤中最具侵入性的類型。 大約50%的星形細胞瘤是多形性神經膠質母細胞瘤,很難治癒[59]。
膠質瘢痕
當損傷和病變組織引起的反應超過了一定的程度或者長期慢性刺激就會引起As的過度增生,繼而形成膠質瘢痕。膠質瘢痕封閉病變組織,防止微生物感染和細胞損傷蔓延。膠質瘢痕同時亦產生CSPG生長抑制因子,會阻止軸突生成和神經發生。膠質瘢痕的形成最終阻礙軸突再生,導致神經功能不能恢復。神經系統疾病如阿爾茨海默病及癲癇等的發生和發展,以及腦血管病或腦外傷的發生均伴隨膠質瘢痕的形成[61]。
培養
星形膠質細胞的培養模式主要有原代星形膠質細胞培養[68]、直接分離培養體內成熟的星形膠質細胞[69],以及神經乾細胞分化[70]三種方式,其中又以第一種方式的使用範圍最廣闊。形態學實驗和免疫螢光結果顯示,原代星形膠質細胞具有分裂迅速、胞體較大、分枝較少且GFAP表達量較高的特點。這與高度分化的反應態星形膠質細胞狀態類似。而神經乾細胞分化而來的星形膠質細胞基本則不具分裂能力,胞體相較於原代細胞小且分枝多,GFAP表達量亦低。這與分化早期的靜息態星形膠質細胞狀態類似。這表明原代星形膠質細胞處於反應態,而分化的星形膠質細胞則未進入反應態。因為原代星形膠質細胞中GS、xCT、N-甲基-D-天門冬胺酸、脂蛋白酶和GFAP等基因的表達水平顯著地高於分化的星形膠質細胞[71]。
研究
羅徹斯特大學的一組科學家於2010年11月進行了一項研究,試圖通過替換神經膠質細胞來修復成年大鼠中樞神經系統的創傷。當將神經膠質細胞注射成年大鼠的脊髓損傷位置時,星形膠質細胞通過將人類神經膠質前體細胞暴露於骨塑型蛋白而產生(骨塑型蛋白可以在整個人體中形成組織結構)。這促進了軸突生長,脊髓板層神經元的存活亦明顯增加。另一方面,神經膠質前體細胞和這些細胞通過與纖毛狀神經營養因子接觸而產生的星形膠質細胞,未能促進神經元存活,反而在損傷部位上促進軸突生長[72]。
有研究涉及了兩種類型的海馬體神經元培養物,在第一種培養物中,神經元是從一層星形膠質細胞生長而來的,而另一種培養物則不與任何星形膠質細胞接觸,而是用具神經膠質條件的培養基(GCM) 。它會抑制培養的星形膠質細胞在大鼠大腦中的生長。在從一層星形膠質細胞生長的培養物中,星形膠質細胞對長期增強作用 (LTP) 具有直接的作用,而在GCM培養物中則沒有[73]。研究表明,星形膠質細胞在神經幹細胞的調節中起重要作用。哈佛大學的一份研究表明,人類腦部中有大量神經幹細胞,通過來自星形膠質細胞的化學信號保持休眠狀態。星形膠質細胞能夠通過抑制Ephrin A2和Ephrin A3的釋放來激活幹細胞轉化為可運作的神經元[74]。
威斯康辛大學的一組研究人員在2011年《自然-生物技術》上發表的一項研究中提到,它已經能夠指導胚胎幹細胞和受誘導的人類幹細胞成為星形膠質細胞[75]。在2012年,一項大麻對短期記憶影響的研究發現,四氫大麻酚激活星形膠質細胞的大麻受體第一型受體,從而導致AMPA受體從相關神經元的細胞膜上被去除[76]。
分類
解剖學分類法
原生質的:在灰質中發現,有許多分支的細胞突起,其末端腳包裹著突觸。側腦室附近的SVX內祖細胞會產生一些原漿性星形膠質細胞[77][78]。
Gömöri陽性星形膠質細胞:即原漿性星形神經膠質細胞的子集,其中包含許多細胞質內含物或顆粒,它們被鉻明礬蘇木精 (chrome-alum hematoxylin) 染色後呈陽性。這些顆粒是由溶酶體內,被吞噬的變性線粒體的殘餘物形成的[79]。某些類型的氧化應激似乎是這些特殊星形膠質細胞內線粒體損傷的原因。與其他大腦區域相比,下丘腦弓狀核和海馬體中Gömöri陽性星形膠質細胞豐富得多。它們可能在調節下丘腦對葡萄糖的反應中起到一定的作用[80][81]。
纖維狀的:存在於白質中,表現出細長而 無分支的細胞突起,其末端腳包着Ranvier節。 放射狀膠質細胞也可產生一些纖維狀星形膠質細胞[82][83][84]。
參考資料
- http://terms.naer.edu.tw/detail/707582/
- Verkhratsky A, Butt AM. . . John Wiley and Sons. 2013: 93–96. ISBN 978-0-470-97853-5.
- Freeman, Marc R.; Rowitch, David H. . Neuron. 2013-10-30, 80 (3): 613–623 [2022-03-07]. ISSN 0896-6273. PMC 5221505
. PMID 24183014. doi:10.1016/j.neuron.2013.10.034. (原始内容存档于2022-06-25). - Wang, Hao; Kulas, Joshua A.; Ferris, Heather A.; Hansen, Scott B. : 2020.06.18.159632. 2020-10-14 [2022-03-07]. doi:10.1101/2020.06.18.159632v2. (原始内容存档于2021-11-13) (英语).
- Sloan, Steven A; Barres, Ben A. . Current opinion in neurobiology. 2014-8, 27: 75–81 [2022-03-07]. ISSN 0959-4388. PMC 4433289
. PMID 24694749. doi:10.1016/j.conb.2014.03.005. (原始内容存档于2022-06-22). - . [27 July 2018]. (原始内容存档于2020-01-28).
- Fiacco TA, Agulhon C, McCarthy KD. . Annual Review of Pharmacology and Toxicology. October 2008, 49 (1): 151–74. PMID 18834310. doi:10.1146/annurev.pharmtox.011008.145602.
- Venkatesh K, Srikanth L, Vengamma B, Chandrasekhar C, Sanjeevkumar A, Mouleshwara Prasad BC, Sarma PV. . Neurology India. 2013, 61 (4): 383–8. PMID 24005729. doi:10.4103/0028-3886.117615.
- Sofroniew, Michael V.; Vinters, Harry V. . Acta Neuropathologica. 2009-12-10, 119 (1): 7–35. doi:10.1007/s00401-009-0619-8.
- Sofroniew MV. . Trends in neurosciences. 2009-12, 32 (12): 638–47 [2019-10-26]. PMID 19782411. doi:10.1016/j.tins.2009.08.002.
- Pellerin L; Bouzier-Sore AK. . Glia. 2007-09, 55 (12): 1251–62. PMID 17659524. doi:10.1002/glia.20528.
- Naff, NJ; Carhuapoma, JR; Williams, MA; Bhardwaj, A; Ulatowski, JA; Bederson, J; Bullock, R; Schmutzhard, E; Pfausler, B; Keyl, PM; Tuhrim, S; Hanley, DF. . Stroke. 2000-04, 31 (4): 841–7 [2019-10-31]. PMID 10753985. doi:10.1161/01.str.31.4.841.
- 李剑锋; 闫金玉等. . 中国组织工程研究. 2016, 20 (37). doi:10.3969/j.issn.2095-4344.2016.37.020.
- Rowitch DH, Kriegstein AR. . Nature. November 2010, 468 (7321): 214–22. Bibcode:2010Natur.468..214R. PMID 21068830. doi:10.1038/nature09611.
- Muroyama Y, Fujiwara Y, Orkin SH, Rowitch DH. . Nature. November 2005, 438 (7066): 360–3. Bibcode:2005Natur.438..360M. PMID 16292311. doi:10.1038/nature04139.
- Hochstim C, Deneen B, Lukaszewicz A, Zhou Q, Anderson DJ. . Cell. May 2008, 133 (3): 510–22. PMC 2394859
. PMID 18455991. doi:10.1016/j.cell.2008.02.046. - Biesiada, E; Razandi, M; Levin, ER. . The Journal of biological chemistry. 1996-08-02, 271 (31): 18576–81. PMID 8702507. doi:10.1074/jbc.271.31.18576.
- Mayer, SI; Rössler, OG; Endo, T; Charnay, P; Thiel, G. . Journal of cell science. 2009-09-15, 122 (Pt 18): 3340–50. PMID 19706684. doi:10.1242/jcs.048272.
- Cakir T, Alsan S, Saybaşili H, Akin A, Ulgen KO. . Theoretical Biology & Medical Modelling. December 2007, 4 (1): 48. PMC 2246127
. PMID 18070347. doi:10.1186/1742-4682-4-48. - Kolb, Brian and Whishaw, Ian Q. (2008) Fundamentals of Human Neuropsychology. Worth Publishers. 6th ed. ISBN 0716795868
- Araque A, Parpura V, Sanzgiri RP, Haydon PG. . Trends in Neurosciences. May 1999, 22 (5): 208–15. PMID 10322493. doi:10.1016/,S0166-2236(98)01349-6.
- Reynolds, Gretchen. . New York Times. 22 February 2012 [2019-10-27]. (原始内容存档于2021-02-26).
- Czech-Damal NU. . Neuroscience. 2014-09-05, 275: 374-383. PMID 24959743. doi:10.1016/j.neuroscience.2014.06.024.
- 趙海軍等. . 卒中與神經疾病. 2015, (6): 382-384 [2019-10-28].
- McDougal DH, Viard E, Hermann GE, Rogers RC. . Autonomic Neuroscience. April 2013, 175 (1–2): 61–9. PMC 3951246
. PMID 23313342. doi:10.1016/j.autneu.2012.12.006. - Kimelberg HK, Jalonen T, Walz W. . Murphy S (编). . San Diego, CA: Academic Press. 1993: 193–222. ISBN 978-0125113700.
- Swaminathan N. . Scientific American Mind. 1 October 2008: 7 [2019-10-27]. (原始内容存档于2017-10-05).
- Figley CR, Stroman PW. . The European Journal of Neuroscience. February 2011, 33 (4): 577–88. PMID 21314846. doi:10.1111/j.1460-9568.2010.07584.x.
- Santello M, Volterra A. . Neuroscience. Mar. January 2009, 158 (1): 253–9. PMID 18455880. doi:10.1016/j.neuroscience.2008.03.039.
- Agulhon C, Fiacco TA, McCarthy KD. . Science. March 2010, 327 (5970): 1250–4. Bibcode:2010Sci...327.1250A. PMID 20203048. doi:10.1126/science.1184821.
- Walz W. . Neurochemistry International. April 2000, 36 (4–5): 291–300. PMID 10732996. doi:10.1016/S0197-0186(99)00137-0.
- Gabriel S, Njunting M, Pomper JK, Merschhemke M, Sanabria ER, Eilers A, Kivi A, Zeller M, Meencke HJ, Cavalheiro EA, Heinemann U, Lehmann TN. . The Journal of Neuroscience. November 2004, 24 (46): 10416–30. PMID 15548657. doi:10.1523/JNEUROSCI.2074-04.2004.
- 李蕊; 胡學強. . 中國神經免疫學和神經病學雜志. 2014, 21 (1): 62–65. doi:10.3969/j.issn.1006-2963.2014.01.017.
- Piet R, Vargová L, Syková E, Poulain DA, Oliet SH. . Proceedings of the National Academy of Sciences of the United States of America. February 2004, 101 (7): 2151–5. Bibcode:2004PNAS..101.2151P. PMC 357067
. PMID 14766975. doi:10.1073/pnas.0308408100. - Pascual O, Casper KB, Kubera C, Zhang J, Revilla-Sanchez R, Sul JY, Takano H, Moss SJ, McCarthy K, Haydon PG. . Science. October 2005, 310 (5745): 113–6. Bibcode:2005Sci...310..113P. PMID 16210541. doi:10.1126/science.1116916.
- Parri R, Crunelli V. . Nature Neuroscience. January 2003, 6 (1): 5–6. PMID 12494240. doi:10.1038/nn0103-5.
- Ishibashi T, Dakin KA, Stevens B, Lee PR, Kozlov SV, Stewart CL, Fields RD. . Neuron. March 2006, 49 (6): 823–32. PMC 1474838
. PMID 16543131. doi:10.1016/j.neuron.2006.02.006. - Anderson MA, Burda JE, Ren Y, Ao Y, O'Shea TM, Kawaguchi R, Coppola G, Khakh BS, Deming TJ, Sofroniew MV. . Nature. April 2016, 532 (7598): 195–200. Bibcode:2016Natur.532..195A. PMC 5243141
. PMID 27027288. doi:10.1038/nature17623. - Liddelow SA, Guttenplan KA, Clarke LE, Bennett FC, Bohlen CJ, Schirmer L, Bennett ML, Münch AE, Chung WS, Peterson TC, Wilton DK, Frouin A, Napier BA, Panicker N, Kumar M, Buckwalter MS, Rowitch DH, Dawson VL, Dawson TM, Stevens B, Barres BA. . Nature. January 2017, 541 (7638): 481–487. Bibcode:2017Natur.541..481L. PMC 5404890
. PMID 28099414. doi:10.1038/nature21029. - Han X, Chen M, Wang F, Windrem M, Wang S, Shanz S, Xu Q, Oberheim NA, Bekar L, Betstadt S, Silva AJ, Takano T, Goldman SA, Nedergaard M. . Cell Stem Cell. March 2013, 12 (3): 342–53. PMC 3700554
. PMID 23472873. doi:10.1016/j.stem.2012.12.015 (英语). - Brancaccio M, Edwards MD, Patton AP, Smyllie NJ, Chesham JE, Maywood ES, Hastings MH. . Science. January 2019, 363 (6423): 187–192. PMC 6440650
. PMID 30630934. doi:10.1126/science.aat4104. - Nossenson N, Magal A, Messer H. . Neurocomputing. 2016, 174: 822–837. doi:10.1016/j.neucom.2015.10.007.
- Nossenson N. (PDF). The Neiman Library of Exact Sciences & Engineering, Tel Aviv University: PhD diss, University of Tel-Aviv. 2013 [2019-11-16]. (原始内容存档 (PDF)于2017-03-05).
- Cornell-Bell AH, Finkbeiner SM, Cooper MS, Smith SJ. . Science. January 1990, 247 (4941): 470–3. Bibcode:1990Sci...247..470C. PMID 1967852. doi:10.1126/science.1967852.
- Jahromi BS, Robitaille R, Charlton MP. . Neuron. June 1992, 8 (6): 1069–77. PMID 1351731. doi:10.1016/0896-6273(92)90128-Z.
- Verkhratsky A, Orkand RK, Kettenmann H. . Physiological Reviews. January 1998, 78 (1): 99–141. PMID 9457170. doi:10.1152/physrev.1998.78.1.99.
- Ebert U, Koch M. . Physiology & Behavior. September 1997, 62 (3): 557–62. PMID 9272664. doi:10.1016/S0031-9384(97)00018-8.
- Frot M, Magnin M, Mauguière F, Garcia-Larrea L. . Cerebral Cortex. March 2007, 17 (3): 610–20. PMID 16614165. doi:10.1093/cercor/bhk007.
- Perlman, Ido. . webvision.med.utah.edu. [2019-11-16]. (原始内容存档于2021-02-13).
- Tian GF, Azmi H, Takano T, Xu Q, Peng W, Lin J, Oberheim N, Lou N, Wang X, Zielke HR, Kang J, Nedergaard M. . Nature Medicine. September 2005, 11 (9): 973–81. PMC 1850946
. PMID 16116433. doi:10.1038/nm1277. - Gorina, R; Font-Nieves, M; Márquez-Kisinousky, L; Santalucia, T; Planas, AM. . Glia. 2011-02, 59 (2): 242–55. PMID 21125645. doi:10.1002/glia.21094.
- Klegeris, A; Giasson, BI; Zhang, H; Maguire, J; Pelech, S; McGeer, PL. . FASEB journal : official publication of the Federation of American Societies for Experimental Biology. 2006-10, 20 (12): 2000–8. PMID 17012252. doi:10.1096/fj.06-6183com.
- 王进堂等. . 中国现代医学杂志. 2018, 28 (17): 26-30. doi:10.3969/j.issn.1005-8982.2018.17.005.
- Ralay Ranaivo, H; Craft, JM; Hu, W; Guo, L; Wing, LK; Van Eldik, LJ; Watterson, DM. . The Journal of neuroscience : the official journal of the Society for Neuroscience. 2006-01-11, 26 (2): 662–70. PMID 16407564. doi:10.1523/JNEUROSCI.4652-05.2006.
- Song, C; Wang, H. . Progress in neuro-psychopharmacology & biological psychiatry. 2011-04-29, 35 (3): 760–8. PMID 20600462. doi:10.1016/j.pnpbp.2010.06.020.
- Zhou, WW; Lu, S; Su, YJ; Xue, D; Yu, XL; Wang, SW; Zhang, H; Xu, PX; Xie, XX; Liu, RT. . Free radical biology & medicine. 2014-09, 74: 50–63. PMID 24960578. doi:10.1016/j.freeradbiomed.2014.06.013.
- Hannestad, J; DellaGioia, N; Bloch, M. . Neuropsychopharmacology : official publication of the American College of Neuropsychopharmacology. 2011-11, 36 (12): 2452–9. PMID 21796103. doi:10.1038/npp.2011.132.
- 呂俊生; 付俊飛等. . 內蒙古醫學雜誌. 2016, 48 (5): 594-595. doi:10.16096/J.cnki.nmgyxzz.2016.48.05.038.
- Astrocytomas 的存檔,存档日期2012-04-05.. International RadioSurgery Association (2010).
- Astrocytoma Tumors (页面存档备份,存于). American Association of Neurological Surgeons (August 2005).
- 康文博等. . 天津醫藥. 215, 43 (6): 694-697. doi:10.11958/j.issn.0253-9896.2015.06.031.
- Barker AJ, Ullian EM. . Communicative & Integrative Biology. 2008, 1 (2): 207–11. PMC 2686024
. PMID 19513261. doi:10.4161/cib.1.2.7284. - Sloan SA, Barres BA. . Current Opinion in Neurobiology. August 2014, 27: 75–81. PMC 4433289
. PMID 24694749. doi:10.1016/j.conb.2014.03.005. - Sofroniew MV. . Cold Spring Harbor Perspectives in Biology. November 2014, 7 (2): a020420. PMC 4315924
. PMID 25380660. doi:10.1101/cshperspect.a020420. - Söllvander, Sofia; Nikitidou, Elisabeth; Brolin, Robin; Söderberg, Linda; Sehlin, Dag; Lannfelt, Lars; Erlandsson, Anna. . Molecular Neurodegeneration. 12 May 2016, 11 (1): 38 [2019-10-28]. ISSN 1750-1326. PMC 4865996
. PMID 27176225. doi:10.1186/s13024-016-0098-z. (原始内容存档于2016-07-01). - Rostami, Jinar; Holmqvist, Staffan; Lindström, Veronica; Sigvardson, Jessica; Westermark, Gunilla T.; Ingelsson, Martin; Bergström, Joakim; Roybon, Laurent; Erlandsson, Anna. . The Journal of Neuroscience. 6 December 2017, 37 (49): 11835–11853. ISSN 1529-2401. PMC 5719970
. PMID 29089438. doi:10.1523/JNEUROSCI.0983-17.2017. - Maragakis, Nicholas J; Rothstein, Jeffrey D. . Nature Clinical Practice Neurology. December 2006, 2 (12): 679–689. ISSN 1745-834X. doi:10.1038/ncpneuro0355.
- McCarthy, KD; de Vellis, J. . The Journal of cell biology. 1980-06, 85 (3): 890–902 [2019-10-31]. PMID 6248568. doi:10.1083/jcb.85.3.890.
- Foo, LC; Allen, NJ; Bushong, EA; Ventura, PB; Chung, WS; Zhou, L; Cahoy, JD; Daneman, R; Zong, H; Ellisman, MH; Barres, BA. . Neuron. 2011-09-08, 71 (5): 799–811. PMID 21903074. doi:10.1016/j.neuron.2011.07.022.
- Emdad, L; D'Souza, SL; Kothari, HP; Qadeer, ZA; Germano, IM. . Stem cells and development. 2012-02-10, 21 (3): 404–10. PMID 21631388. doi:10.1089/scd.2010.0560.
- 沈慧; 許琪. . 中國醫學科學院學報. 2019, 41 (4): 524–528. doi:10.3881/j.issn.1000-503X.11015.
- Davies SJ, Shih CH, Noble M, Mayer-Proschel M, Davies JE, Proschel C. Combs C , 编. . PLOS ONE. March 2011, 6 (3): e17328. Bibcode:2011PLoSO...617328D. PMC 3047562
. PMID 21407803. doi:10.1371/journal.pone.0017328. - Yang Y, Ge W, Chen Y, Zhang Z, Shen W, Wu C, Poo M, Duan S. . Proceedings of the National Academy of Sciences of the United States of America. December 2003, 100 (25): 15194–9. Bibcode:2003PNAS..10015194Y. PMC 299953
. PMID 14638938. doi:10.1073/pnas.2431073100. - Jiao JW, Feldheim DA, Chen DF. . Proceedings of the National Academy of Sciences of the United States of America. June 2008, 105 (25): 8778–83. Bibcode:2008PNAS..105.8778J. PMC 2438395
. PMID 18562299. doi:10.1073/pnas.0708861105. - Krencik R, Weick JP, Liu Y, Zhang ZJ, Zhang SC. . Nature Biotechnology. May 2011, 29 (6): 528–34. PMC 3111840
. PMID 21602806. doi:10.1038/nbt.1877.. Lay summary: Human Astrocytes Cultivated From Stem Cells In Lab Dish by U of Wisconsin Researchers (页面存档备份,存于). sciencedebate.com (22 May 2011) - Han J, Kesner P, Metna-Laurent M, Duan T, Xu L, Georges F, Koehl M, Abrous DN, Mendizabal-Zubiaga J, Grandes P, Liu Q, Bai G, Wang W, Xiong L, Ren W, Marsicano G, Zhang X. . Cell. March 2012, 148 (5): 1039–50. PMID 22385967. doi:10.1016/j.cell.2012.01.037.
- Levison SW, Goldman JE. . Neuron. February 1993, 10 (2): 201–12. PMID 8439409. doi:10.1016/0896-6273(93)90311-E.
- Zerlin M, Levison SW, Goldman JE. . The Journal of Neuroscience. November 1995, 15 (11): 7238–49. PMID 7472478. doi:10.1523/JNEUROSCI.15-11-07238.1995.
- Brawer JR, Stein R, Small L, Cissé S, Schipper HM. . The Anatomical Record. November 1994, 240 (3): 407–15. PMID 7825737. doi:10.1002/ar.1092400313.
- Young JK, McKenzie JC. . The Journal of Histochemistry and Cytochemistry. November 2004, 52 (11): 1519–24. PMC 3957823
. PMID 15505347. doi:10.1369/jhc.4A6375.2004. - Marty N, Dallaporta M, Foretz M, Emery M, Tarussio D, Bady I, Binnert C, Beermann F, Thorens B. . The Journal of Clinical Investigation. December 2005, 115 (12): 3545–53. PMC 1297256
. PMID 16322792. doi:10.1172/jci26309. - Misson JP, Edwards MA, Yamamoto M, Caviness VS. . Brain Research. Developmental Brain Research. November 1988, 44 (1): 95–108. PMID 3069243. doi:10.1016/0165-3806(88)90121-6.
- Voigt T. . The Journal of Comparative Neurology. November 1989, 289 (1): 74–88. PMID 2808761. doi:10.1002/cne.902890106.
- Goldman SA, Zukhar A, Barami K, Mikawa T, Niedzwiecki D. . Journal of Neurobiology. August 1996, 30 (4): 505–20. PMID 8844514. doi:10.1002/(SICI)1097-4695(199608)30:4<505::AID-NEU6>3.0.CO;2-7.
- Cisneros IE, Ghorpade A. . Neuropharmacology. October 2014, 85: 499–507. PMC 4315503
. PMID 24950453. doi:10.1016/j.neuropharm.2014.06.011.
延伸閱讀
- Choi BH, Lapham LW. . Brain Research. June 1978, 148 (2): 295–311. PMID 77708. doi:10.1016/0006-8993(78)90721-7.
- Schmechel DE, Rakic P. . Anatomy and Embryology. June 1979, 156 (2): 115–52. PMID 111580. doi:10.1007/BF00300010.
- White, F.A., Jung, H. and Miller, R.J. . Proceedings of the National Academy of Sciences of the United States of America. 2007, 104 (51): 20151–20158. PMC 2154400
. PMID 18083844. doi:10.1073/pnas.0709250104. - Milligan, E.D. and Watson, L.R. . Neuron-Glia Interactions. 2009, 10 (1): 23–36. PMC 2752436
. PMID 19096368. doi:10.1038/nrn2533. - Watkins, L.R., Milligan, E.D. and Maier, S.F. . Trends in Neurosci. 2001, 24 (8): 450–455. PMID 11476884. doi:10.1016/S0166-2236(00)01854-3.
- Freeman, M. R. . Science. 2010, 330 (6005): 774–8. PMID 21051628. doi:10.1126/science.1190928.
- Verkhratsky, A., Butt, A.M. . . John Wiley and Sons. 2013: 93–96. ISBN 978-0-470-97853-5.
外部連結
| 维基共享资源上的相关多媒体资源:星形膠質細胞 |
- Cell Centered Database – Astrocyte (页面存档备份,存于)
- UIUC組織學主題 57
- "Astrocytes" (页面存档备份,存于) at Society for Neuroscience
- NIF Search – Astrocyte (页面存档备份,存于) via the Neuroscience Information Framework


